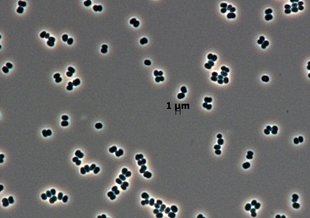
Cells of tersicoccus phoenicis, a rare microbe found in clean rooms in South America and Florida. The latest microscopic technology can isolate individual microbes from their colonies, improving the search for life on other worlds in the future.

News & Discoveries

Distinguishing Between Bacterial and Eukaryotic SterolsJuly 12, 2018

Life History Strategies in Benthic Marine InvertebratesJuly 11, 2018

Planetary Protection of Ocean WorldsJuly 10, 2018

Exoplanet Science Flying HighJuly 9, 2018
Electron Acceptors and Carbon Sources for a Thermoacidophilic ArchaeaJuly 5, 2018

Theories on the Origin of an Interstellar Small BodyJuly 2, 2018

Will We Know Life When We See It?July 2, 2018

Asteroid Remains Around Dead Stars Reveal the Likely Fate of Our Solar SystemJune 30, 2018

Rapid Alteration of MeteoritesJune 29, 2018

How Microbes From Spacecrafts Survive Clean RoomsJune 28, 2018

Photochemistry of Bacterial DNA under Mars ConditionsJune 27, 2018

The Potential for Metal Contamination in Apollo SamplesJune 26, 2018
Resources



